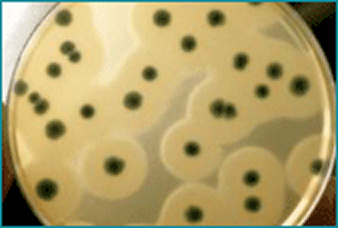
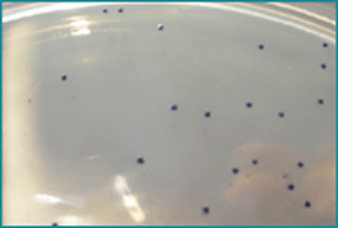
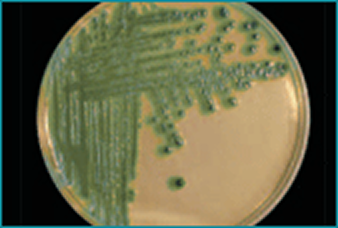

>> Sal del matrix de la incertidumbre en tus resultados
¿Sabías que 3 de cada 10 análisis microbiológicos son falsos positivos, falsos negativos o recuentos inexactos, por seguir protocolos oficiales obsoletos, o con puntos críticos?


>> Hay que cambiar esto.
Estar estancado en protocolos clásicos que dan falsos resultados, altera la realidad.
No es admisible que mis errores repercutan en los demás. A partir de ahora, los errores sistemáticos no caben en nuestra empresa. Y voy a ir de la mano de MICROKIT para implementar los cambios necesarios para conseguir la excelencia en los resultados.

- ¿Quieres salir de ese matrix que da por normal la incertidumbre en tus resultados?
- ¿Quieres aumentar la fiabilidad de tus resultados?
- ¿Quieres estar en ese nivel élite del 7% de laboratorios que alcanzan la excelencia en sus resultados?
Únete a la Comunidad de la Innovación, la corriente que te lleva, paso a paso, a la “V” de la Victoria. La innovación te lleva a otro nivel. Entra en la élite de la microbiología de la mano de MICROKIT.
Puedes descargarte los documentos informativos en pdf de nuestros productos. Puedes hacer clic en la imagen o en el nombre del producto.
- Folleto Resumen Microkit
- PRODUCTOS MICROKIT ELEGIDOS POR LOS LABS COSMÉTICOS
- PRODUCTOS MICROKIT EXCLUSIVOS, PARA ALIMENTOS, CON SUS VENTAJAS DIFERENCIALES
- PRODUCTOS MICROKIT ELEGIDOS POR LOS LABS ACREDITADOS ISO 17025
- PRODUCTOS MICROKIT EXCLUSIVOS, PARA AGUAS, CON SUS VENTAJAS DIFERENCIALES
- PRODUCTOS MICROKIT EXCLUSIVOS, PARA MEDICAMENTOS, CON SUS VENTAJAS DIFERENCIALES

AIRESANO AIRESANO 2021

ANÁLISIS MICROBIOLÓGICOS KOSMLABS

CASSETTES

CEPAS CUANTITATIVAS

COSMETIKIT

COSMETIKIT WATER

CRIOTECA Y ANAEROTECA
CROMOCITOGENES

CROMOKIT
CROMOKIT X STAPH AGAR
CROMOSALM

DESINFECTEST

DRINKING WATER KIT

